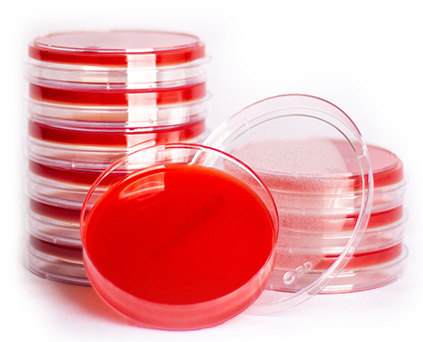

Sheep Blood Agar Plates - 500 Milliliter Plastic , 50 Plates For Growing Fastidious Organisms And Differentiating Bacteria By Hemolytic Properties
Price: 57.00 INR / Piece
(57.00 INR + 0% GST)
Get Latest Price
Minimum Pack Size :
1000
In Stock
Product Specifications
Specimen Size | 50 plates |
Material | Plastic |
Capacity | 500 Milliliter (ML) |
Usage | Blood Agar is used to grow fastidious organisms and to differentiate bacteria based on their hemolytic properties. |
Product Type | Plate |
Payment Terms | Cash in Advance (CID) |
Supply Ability | 10 Per Day |
Delivery Time | 10 Days |
Sample Available | Yes |
Sample Policy | Sample costs shipping and taxes has to be paid by the buyer |
Packaging Details | 50 plates |
Main Export Market(s) | Asia |
Main Domestic Market | North India |
Certifications | ISO Certificated |
Mop | 1000 |
Price | 57.00 INR (Approx.) |
Unit Type | Piece/Pieces |
Currency | INR |
Price Type | fixed |
Moq | 1000 |
Product Unit | 1000 Piece/Pieces |
Returnable | No |
Stock Quantity | 5000 |
Brand Name | Lab line |
Minimum Ordered Packs | 1000 |
Minimum Order Quantity | 1000 |
GSTIN | 0% |
Product Overview
Key Features
bacteria based on their thrombolytic properties. SBAP tests the ability of an organism to produce hemolysins,
enzymes that damage/lye red blood cells (erythrocytes). The degree of hydrolysis by these hemoglobin is helpful
in differentiating members of the genera Staphylococcus, Streptococcus and Enterococcus.
Company Details
Business Type
Supplier, Trading Company
Employee Count
10
Establishment
2013
Working Days
Monday To Saturday
GST NO
07COZPS1065Q1ZR
Payment Mode
Cash Against Delivery (CAD), Cash on Delivery (COD), Cash Advance (CA), Cheque, Delivery Point (DP)
Related Products
Explore Related Categories
More Product From This seller
Seller Details
GST - 07COZPS1065Q1ZR
Delhi, Delhi
Accepts only Domestic inquiries
Proprietor
Mr Deepak
Address
B No - 33A, Street No-2, Prem Nagar, Nathupura, Burari, Delhi, Delhi, 110084, India
bio culture in Delhi
Report incorrect details